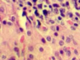
Сахарный диабет: как удержать под контролем

Архив >> 11 июня 2013 г.
Статьи
-
В настоящее время открыто и успешно функционируют 55 образовательных центров в 46 городах России. Только в 2012 году обучение в них прошли более 20 тысяч пациентов. Исследование, проведенное для оценки качества работы центров, показало, что 75 процентов пациентов, прошедших обучение, кардинально изменили свой образ жизни и улучшили ее качество.
В настоящее время открыто и успешно функционируют 55 образовательных центров в 46 городах России. Только в 2012 году обучение в них прошли более 20 тысяч пациентов. Исследование, проведенное для оценки качества работы центров, показало, что 75 процентов пациентов, прошедших обучение, кардинально изменили свой образ жизни и улучшили ее качество.
-
 Излечим ли туберкулез во втором десятилетии двадцать первого века? Как сегодня чаще всего происходит заражение? Может или нет заразиться новорожденный ребенок? Растет или снижается распространенность этой болезни? Могут ли страны заражать друг друга? На эти и другие вопросы специально для читателей MedPulse отвечает врач-фтизиатр Леонид Потапов.
Излечим ли туберкулез во втором десятилетии двадцать первого века? Как сегодня чаще всего происходит заражение? Может или нет заразиться новорожденный ребенок? Растет или снижается распространенность этой болезни? Могут ли страны заражать друг друга? На эти и другие вопросы специально для читателей MedPulse отвечает врач-фтизиатр Леонид Потапов.
Лечение геморроя


 Грибок на ногах
Грибок на ногах




 Косоглазие: глазки врозь и в кучку
Если появилась горошина на веке
Чем опасен просмотр 3D-фильмов
Офтальмологи переходят на "новый уровень"
Как сохранить здоровье глаз надолго
Косоглазие: глазки врозь и в кучку
Если появилась горошина на веке
Чем опасен просмотр 3D-фильмов
Офтальмологи переходят на "новый уровень"
Как сохранить здоровье глаз надолго


 Грибок на ногах
Грибок на ногах




 Косоглазие: глазки врозь и в кучку
Если появилась горошина на веке
Чем опасен просмотр 3D-фильмов
Офтальмологи переходят на "новый уровень"
Как сохранить здоровье глаз надолго
Косоглазие: глазки врозь и в кучку
Если появилась горошина на веке
Чем опасен просмотр 3D-фильмов
Офтальмологи переходят на "новый уровень"
Как сохранить здоровье глаз надолго